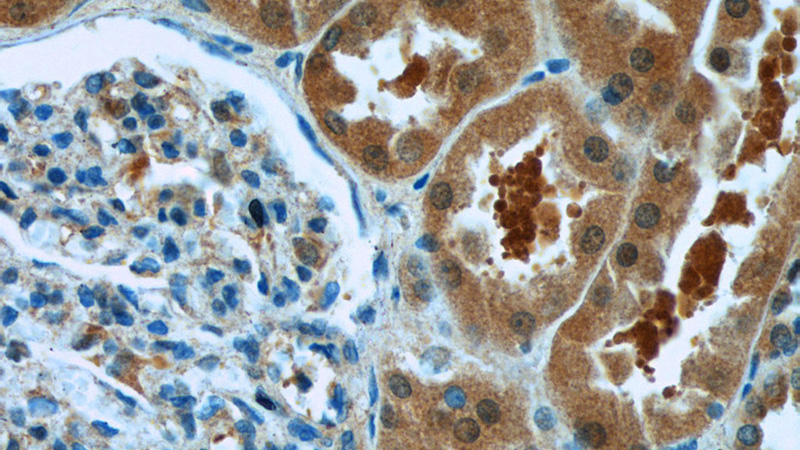

-
Product Name
PARK7,DJ-1 antibody
- Documents
-
Description
PARK7,DJ-1 Rabbit Polyclonal antibody. Positive WB detected in HeLa cells, HEK-293 cells, Jurkat cells. Positive IP detected in HeLa cells. Positive IF detected in SH-SY5Y cells. Positive IHC detected in human gliomas tissue, human kidney tissue. Observed molecular weight by Western-blot: 20 kDa, 25 kDa
-
Tested applications
ELISA, WB, IHC, IP, IF
-
Species reactivity
Human, Mouse; other species not tested.
-
Alternative names
DJ 1 antibody; DJ1 antibody; FLJ27376 antibody; FLJ34360 antibody; FLJ92274 antibody; Oncogene DJ1 antibody; PARK7 antibody; Parkinson disease protein 7 antibody; Protein DJ 1 antibody
-
Isotype
Rabbit IgG
-
Preparation
This antibody was obtained by immunization of PARK7,DJ-1 recombinant protein (Accession Number: NM_007262). Purification method: Antigen affinity purified.
-
Clonality
Polyclonal
-
Formulation
PBS with 0.1% sodium azide and 50% glycerol pH 7.3.
-
Storage instructions
Store at -20℃. DO NOT ALIQUOT
-
Applications
Recommended Dilution:
WB: 1:500-1:5000
IP: 1:500-1:5000
IHC: 1:20-1:200
IF: 1:20-1:200
-
Validations

HeLa cells were subjected to SDS PAGE followed by western blot with Catalog No:113584(PARK7,DJ-1 antibody) at dilution of 1:1000

IP Result of anti-PARK7,DJ-1 (IP:Catalog No:113584, 4ug; Detection:Catalog No:113584 1:1000) with HeLa cells lysate 1200ug.
Immunohistochemistry of paraffin-embedded human kidney tissue slide using Catalog No:113584(PARK7,DJ-1 Antibody) at dilution of 1:50 (under 40x lens)

Immunohistochemistry of paraffin-embedded human gliomas tissue slide using Catalog No:113584(PARK7,DJ-1 Antibody) at dilution of 1:50 (under 40x lens)

Immunofluorescent analysis of SH-SY5Y cells using Catalog No:113584(PARK7,DJ-1 Antibody) at dilution of 1:50 and Alexa Fluor 488-congugated AffiniPure Goat Anti-Rabbit IgG(H+L)
-
Background
PARK7, also named as DJ1, belongs to the peptidase C56 family. It protects cells against oxidative stress and cell death. PARK7 plays a role in regulating expression or stability of the mitochondrial uncoupling proteins SLC25A14 and SLC25A27 in dopaminergic neurons of the substantia nigra pars compacta and attenuates the oxidative stress induced by calcium entry into the neurons via L-type channels during pacemaking. It eliminates hydrogen peroxide and protects cells against hydrogen peroxide-induced cell death. PARK7 has cell-growth promoting activity and transforming activity. It may function as a redox-sensitive chaperone. It's precursor undergoes a cleavage of a C-terminal peptide and subsequent activation of protease activity in response to oxidative stress. The amino acid replace at 166 (L → P) reduces PARK7 protein stability and leads to increased degradation.
-
References
- Björkblom B, Maple-Grødem J, Puno MR, Odell M, Larsen JP, Møller SG. Reactive oxygen species-mediated DJ-1 monomerization modulates intracellular trafficking involving karyopherin β2. Molecular and cellular biology. 34(16):3024-40. 2014.
- Liu S, Long G, Wei H. DJ-1 knockdown inhibits growth and xenograft‑induced tumor generation of human hepatocellular carcinoma cells. Oncology reports. 33(1):201-6. 2015.
- Shiau JY, Yin SY, Chang SL. Mechanistic Study of the Phytocompound, 2- β -D-Glucopyranosyloxy-1-hydroxytrideca-5,7,9,11-tetrayne in Human T-Cell Acute Lymphocytic Leukemia Cells by Using Combined Differential Proteomics and Bioinformatics Approaches. Evidence-based complementary and alternative medicine : eCAM. 2015:475610. 2015.
Related Products / Services
Please note: All products are "FOR RESEARCH USE ONLY AND ARE NOT INTENDED FOR DIAGNOSTIC OR THERAPEUTIC USE"
